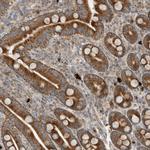
CPAMD8 Antibody in Immunohistochemistry (Paraffin) (IHC (P))

Search
Invitrogen
CPAMD8 Polyclonal Antibody
{{$productOrderCtrl.translations['antibody.pdp.commerceCard.promotion.promotions']}}
{{$productOrderCtrl.translations['antibody.pdp.commerceCard.promotion.viewpromo']}}
{{$productOrderCtrl.translations['antibody.pdp.commerceCard.promotion.promocode']}}: {{promo.promoCode}} {{promo.promoTitle}} {{promo.promoDescription}}. {{$productOrderCtrl.translations['antibody.pdp.commerceCard.promotion.learnmore']}}

Please note: We are reviewing Western blot images included in the antibody testing data in our catalog, including those provided by third parties. Unless expressly labeled or annotated as “raw-unedited”, Western blot images included in the antibody testing data in our catalog may have been edited, optimized or otherwise adjusted for presentation.
产品信息
PA5-56706
种属反应
宿主/亚型
分类
类型
抗原
偶联物
形式
浓度
规格
纯化类型
保存液
内含物
保存条件
运输条件
RRID
产品详细信息
Immunogen sequence: FPETWIWHCL NISDPSGEGT LSVKVPDSIT SWVGEAVALS TSQGLGIAEP SLLKTFKPFF VDFMLPALII RGEQVKIPLS VYNYMGTCAE VYMKLSVPK
Highest antigen sequence identity to the following orthologs: Mouse - 42%, Rat - 42%.
靶标信息
The CPAMD8 gene, known as C3 and pregnancy zone protein-like alpha-2-macroglobulin domain-containing 8, is involved in the development of ocular tissues. It has been linked to anterior segment dysgenesis (ASD) and congenital glaucoma, indicating its critical role in eye development. CPAMD8 functions primarily within the non-pigmented epithelium and might participate in cellular communication and structural integrity during the differentiation of retinal organoids. Loss-of-function mutations in CPAMD8 disrupt normal eye formation, leading to various ocular disorders. Recent advancements, such as the establishment of CPAMD8-GFP reporter human embryonic stem cell lines, enable real-time monitoring of its expression, thereby facilitating exploration of its biological functions in retinal differentiation processes. Bioinformatic evaluations and CRISPR/Cas9 technology have provided insights into CPAMD8's role in eye development, with gene editing approaches helping delineate its involvement in ocular health and disease.
仅用于科研。不用于诊断过程。未经明确授权不得转售。
篇参考文献 (0)
生物信息学
蛋白别名: C3 and PZP-like alpha-2-macroglobulin domain-containing protein 8
基因别名: CPAMD8; KIAA1283
Entrez Gene ID: (Human) 27151




